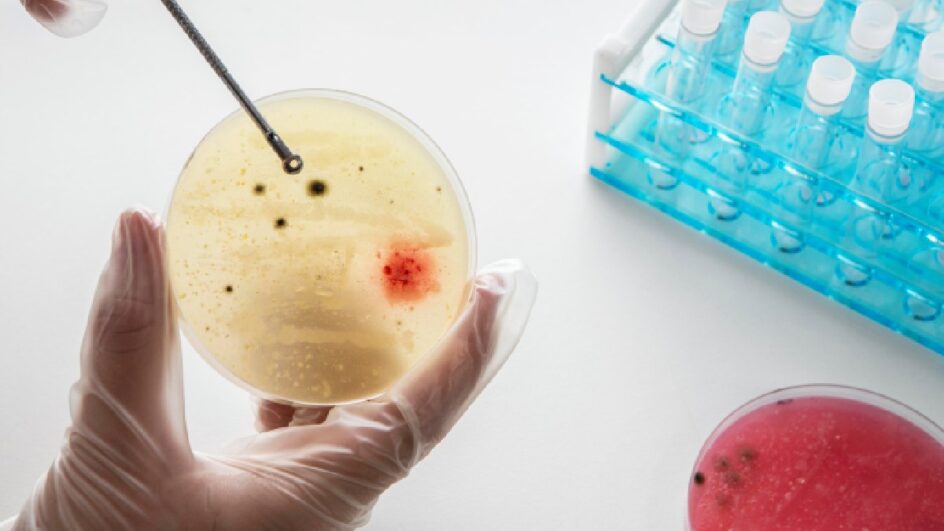
Cientistas estão recriando o início da vida em laboratório (Foto: Banco de Imagens)

Cientistas em Israel alcançaram um feito notável: criaram os primeiros “embriões sintéticos” do mundo, eliminando a necessidade de espermatozoides e óvulos.
Continua depois da publicidade
Essa inovação utiliza células-tronco de camundongos para formar estruturas surpreendentes, que incluem um cérebro inicial, um coração batendo e até um trato intestinal.
Conhecidas como “embriões sintéticos” por serem geradas sem óvulos fertilizados, essas estruturas prometem uma compreensão mais profunda de como os órgãos e tecidos se formam durante o desenvolvimento natural de embriões.
A pesquisa e sua intenção
O estudo foi publicado na renomada revista Cell, confirmando a relevância da pesquisa. Ela foi liderada pelo professor Jacob Hanna no Instituto Weizmann e visa não só aprimorar nosso conhecimento sobre o desenvolvimento embrionário, mas também reduzir os experimentos com animais.
Continua depois da publicidade
Essa pesquisa abre caminho para novas fontes de células e tecidos essenciais para futuros transplantes em humanos. “Estamos muito animados com este trabalho”, acrescentou Hanna, destacando o impacto do estudo.
O que são embriões sintéticos?
São estruturas semelhantes a embriões iniciais, desenvolvidas a partir de células-tronco de camundongos, sem qualquer fertilização tradicional. A equipe utilizou um útero mecânico, o mesmo usado em pesquisas anteriores, para nutrir essas células por mais de uma semana em um ambiente controlado.
Embora a maioria das células-tronco não tenha formado estruturas complexas, uma pequena porcentagem, cerca de 0,5%, desenvolveu tecidos e órgãos notavelmente organizados.
Continua depois da publicidade
Os cientistas afirmam que os órgãos formados eram funcionais, um avanço significativo para a bioengenharia.
Potencial e limitações da descoberta
Esta tecnologia inovadora pode gerar uma compreensão mais profunda de como os órgãos se formam no início da vida, impactando diretamente o estudo do desenvolvimento embrionário natural. Mostramos que células-tronco embrionárias criam embriões sintéticos inteiros, afirmou o professor Jacob Hanna.
Contudo, ele esclareceu que esses “embriões sintéticos” não são “reais” e, portanto, não possuem potencial para se desenvolverem em animais vivos, o que é um ponto crucial.
Continua depois da publicidade
Comparados aos embriões naturais de camundongo, os embriões sintéticos eram 95% idênticos em termos de estrutura interna e perfil genético das células. Isso demonstra a precisão e a semelhança alcançadas pela equipe, consolidando a importância deste estudo revolucionário.
Leia também
Teste de 1 minuto prevê sua expectativa de vida
O alerta dos médicos para essa bebida que pode causar câncer de intestino precoce